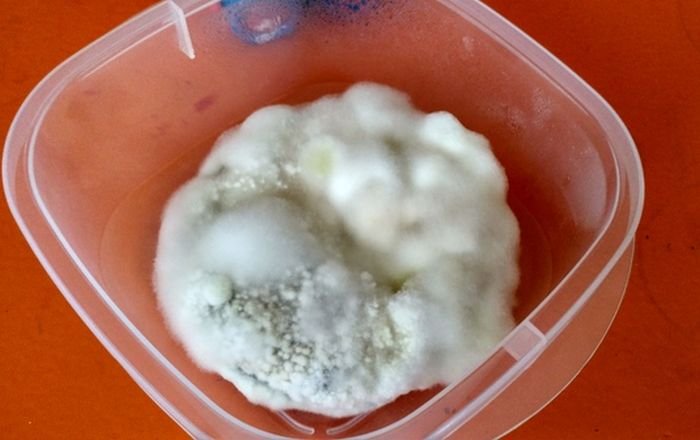

Начитавшись в интернете постов о том, как долго может сохранять безупречный внешний вид еда из фастфуда, житель Торонто, Канада, решил провести свой эксперимент. Купленный в Макдональдсе гамбургер он поместил в пластиковую коробочку для пищевых продуктов и в течение нескольких месяцев держал при комнатной температуре. Что из этого получилось, смотрим далее.